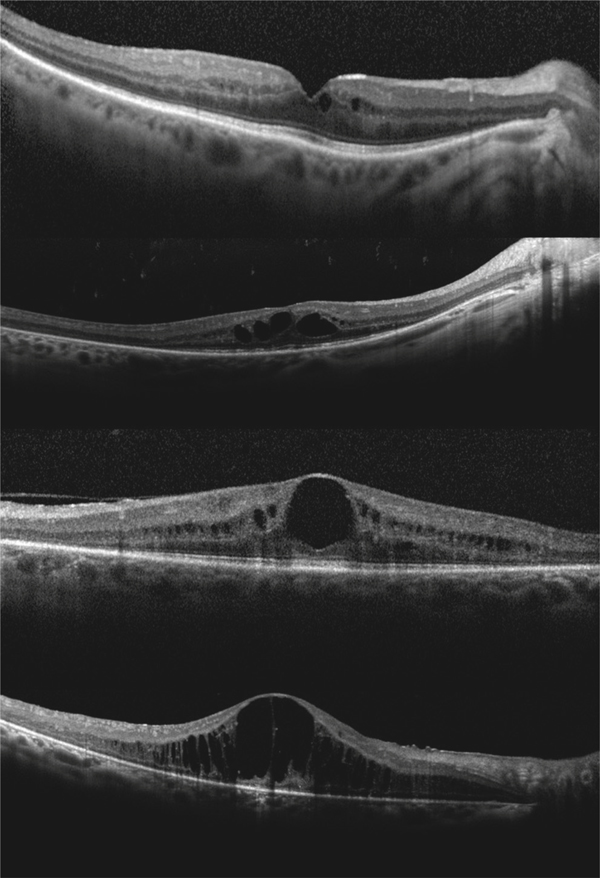
Rapport Sfo 2016 œdemes Maculaires

Your Oedemes maculaires aspects cliniques images are available in this site. Oedemes maculaires aspects cliniques are a topic that is being searched for and liked by netizens today. You can Find and Download the Oedemes maculaires aspects cliniques files here. Find and Download all free photos.
If you’re searching for oedemes maculaires aspects cliniques images information linked to the oedemes maculaires aspects cliniques interest, you have come to the right site. Our website always provides you with suggestions for downloading the highest quality video and picture content, please kindly surf and locate more enlightening video content and graphics that match your interests.
Oedemes Maculaires Aspects Cliniques.
 Manifestations Cliniques Paradoxales Des Biotherapies By Francis Berenbaum Issuu From issuu.com
Manifestations Cliniques Paradoxales Des Biotherapies By Francis Berenbaum Issuu From issuu.com
Source: em-consulte.com
Source: em-consulte.com
 Source: sciencedirect.com
Source: sciencedirect.com
 Source: researchgate.net
Source: researchgate.net
 Source: polevision.fr
Source: polevision.fr
 Source: wikimedi.ca
Source: wikimedi.ca
 Source: chups.jussieu.fr
Source: chups.jussieu.fr
 Source: sfo-online.fr
Source: sfo-online.fr

 Source: em-consulte.com
Source: em-consulte.com
 Source: em-consulte.com
Source: em-consulte.com
 Source: em-consulte.com
Source: em-consulte.com
 Source: sciencedirect.com
Source: sciencedirect.com
 Source: latunisiemedicale.com
Source: latunisiemedicale.com

 Source: livres-medicaux.com
Source: livres-medicaux.com
 Source: clemedicine.com
Source: clemedicine.com
 Source: issuu.com
Source: issuu.com
 Source: realites-ophtalmologiques.com
Source: realites-ophtalmologiques.com
This site is an open community for users to submit their favorite wallpapers on the internet, all images or pictures in this website are for personal wallpaper use only, it is stricly prohibited to use this wallpaper for commercial purposes, if you are the author and find this image is shared without your permission, please kindly raise a DMCA report to Us.
If you find this site convienient, please support us by sharing this posts to your favorite social media accounts like Facebook, Instagram and so on or you can also save this blog page with the title oedemes maculaires aspects cliniques by using Ctrl + D for devices a laptop with a Windows operating system or Command + D for laptops with an Apple operating system. If you use a smartphone, you can also use the drawer menu of the browser you are using. Whether it’s a Windows, Mac, iOS or Android operating system, you will still be able to bookmark this website.






